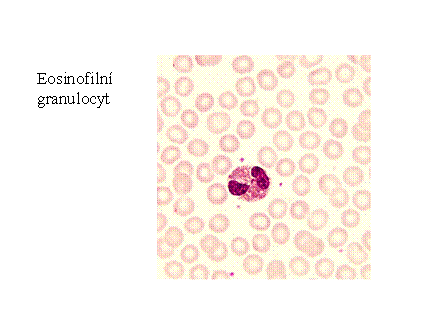

Abstrakt
Granulocyty patří mezi leukocyty, které mají členité jádro,
jsou to tzv. polynukleáry. Obsahují lyzozymy a sekreční granula v cytoplazmě.
Podle barvitelnosti granul jsou rozlišovány na neutrofily (mají fialová
granula), které pohlcují a ničí bakterie, na eozinofily (mají oranžová až
písková granula), které
narušují větší parazity
a účastní se zánětlivých reakcí a na bazofily (mají hrubá hnědočervená
granula), které uvolňují ze sekrečních granulí histamin a serotonin.
Odkazy na jiné
relevantní dokumenty, další informace
Popis zralých periferních krevních buněk

Autorské poznámky
Ilona Fátorová, Eva
Fenclová